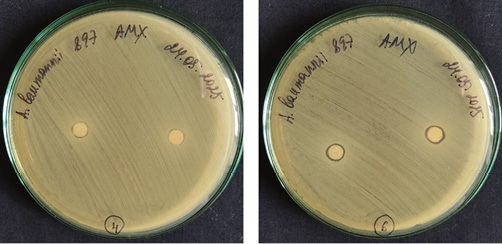

Scroll to:
Honey-based hydrogel: A promising new-generation antimicrobial coating?
https://doi.org/10.47183/mes.2025-347
Abstract
Introduction. The development of hydrogel coatings is a promising research direction in burn injury therapy. Honey-based hydrogels possess unique physicochemical characteristics due to being transparent, capable of effectively absorbing exudate, and exhibiting low pH values. All these properties make them ideal candidates for application not only in cosmetology but also in medicine for the transdermal delivery of various medicinal substances.
Objective. Synthesis of honey-based hydrogels and comparative analysis of their physicochemical characteristics and antibacterial activity.
Materials and methods. Hydrogels were synthesized based on chitosan and сarbopol with addition of 25, 50, and 75 wt % of white honey. The following parameters were investigated: viscosity (using a Brookfield rotational viscometer); spreadability (by a compression method); degree of sample swelling; stability (by centrifugation); honey release from the sample (using an ERWEKA DT-820 tester); analysis of the quantitative honey content in the buffer (by spectrophotometry). The study of in vitro antibacterial properties was conducted using Candida albicans ATCC 64550 (a yeast-like fungus), Staphylococcus aureus ATCC 25913 (a gram-positive bacterium), Escherichia coli ATCC 25922 (a gram-negative bacterium), Acinetobacter baumannii 897 (a gram-negative bacterium), Enterobacter cloacae ATCC 13047 (a gram-negative bacterium), Klebsiella pneumoniae ATCC 19606 (a gram-negative bacterium). Statistical data processing was performed using the DeltaX 3.0 software.
Results. In terms of viscosity, the hydrogel based on 1% Carbopol 940 with a honey concentration of 25 wt % outperformed other gels. The samples based on 1% Carbopol ETD 2020 with a honey concentration of 50 wt % exhibited the lowest spreadability. The highest sorption capacity 1 h and 3 h after the onset of testing was demonstrated by the sample based on 3.5% low-viscosity chitosan with a honey concentration of 25 wt %. The highest honey release was shown by the sample based on 10% low-viscosity chitosan with a honey concentration of 50 wt %.
Conclusions. The conducted study of physicochemical and antibacterial properties render chitosan-based hydrogels promising for further investigation. Hydrogel samples with a 75% honey concentration failed the stability test, which make them unsuitable for use as a therapeutic delivery system. Based on the results obtained, a mixed hydrogel based on Carbopol 940 and 3.5% low-viscosity chitosan is recommended for further research.
For citations:
Karpina E.N., Fedotova E.V., Zaripova F.F., Krivorotov D.V., Radilov A.S. Honey-based hydrogel: A promising new-generation antimicrobial coating? Extreme Medicine. 2026;28(1):146-156. https://doi.org/10.47183/mes.2025-347
INTRODUCTION
Burns are one of the most common types of injuries, both in domestic and industrial settings. In combustiology, burns are classified into chemical, thermal, radiation, and combined types. Susceptibility to infection by various bacteria and the need to stimulate skin regeneration are unifying factors for all these groups.
Hydrogels possess a number of properties that underpin their advantages for use in combustiology. These include absorption capacity, biodegradability, affinity to the extracellular matrix ensuring biocompatibility, non-adhesiveness, and the ability to deliver antimicrobial components directly to the site of injury [1–3]. These properties determine the potential efficacy of hydrogel applications in burn care.
Hydrogels based on smart polymers capable of responding to external stimuli, such as pH level, temperature, and reactive oxygen species (ROS) concentration, are increasingly attracting the research attention [3]. One promising direction involves the development of synthetic hydrogels with programmed release of bioactive substances capable of influencing the pathogenesis of the wound healing process [4].
The ability of hydrogels to absorb fluids and swell allows a specific moisture level to be maintained. This facilitates control over exudate levels and ensures necessary solubilization. The biocompatibility of hydrogel-based polymers is important for mitigating the risk of immune response induction and rejection by the body.
Polymeric hydrogel coatings effectively bind with various bioactive and pharmaceutical substances, enabling the delivery of antimicrobial, anti-inflammatory, analgesic, and other therapeutic agents directly to the affected area [5]. Certain hydrogels can also exhibit intrinsic antibacterial properties, such as synthetic polymeric hydrogels based on poly(2-hydroxyethyl methacrylate) [4]. Maikovych et al. also demonstrated the antibacterial effect of hydrogels based on gelatin cross-linked with polyethylene glycol against S. aureus and E. coli [6].
As a rule, hydrogels for burn care are fabricated from natural polymers such as chitosan, sodium alginate, collagen, hyaluronic acid, cellulose, gelatin, etc. Synthetic polymers including polyvinyl alcohol, polyacrylamide, polyethylene glycol, and carbopol may also hold promise in this field. Currently, hybrid hydrogels are among the most widely used. These are created by combining two or more synthetic and natural polymers. By leveraging the physicochemical properties of the constituent polymers, the application scope of such hybrid hydrogels can be tailored [7]. One example of such combinations is a hydrogel based on carboxymethyl cellulose and chitosan, formed via a Schiff base reaction. This hydrogel was recommended for the healing of deep burns due to its excellent tissue adhesion [8].
The antibacterial properties of honey have long been of interest to researchers. Its effectiveness against both pathogenic and non-pathogenic microorganisms, including bacteria, yeasts, and fungi, has been demonstrated in numerous scientific studies. The antimicrobial activity honey is associated with low pH values (acidic environment), the content of hydrogen peroxide, sugars, and protein [9]. The high content of sugar creates a protective barrier to inhibit the development of microorganisms. The reduction in the amount of unbound water molecules in honey leads to suppressed microbial growth and proliferation [10]. The antifungal properties of honey are also linked to its physicochemical characteristics. Phenolic compounds present in honey are believed to contribute to protein denaturation, significantly destabilizing cellular membranes and ultimately leading to their disruption in fungi [11][12].
The anti-inflammatory properties of honey are equally relevant to burn medicine. Inflammation is a process driven by immune response to various injuries or the invasion of foreign pathogenic microorganisms. The mitigating effect of honey on the inflammatory process is thought to be associated with its phenolic constituents. Galangin (one of the honey flavonoids) inhibits the activity of cyclooxygenase (COX) and lipoxygenase-2, reduces the expression of cyclooxygenase-2 (COX-2), and restrains the action of polygalacturonase [13]. Some authors attribute the effect of honey on the molecular mechanisms underlying the immune response to the induction of NF-κB (a transcription factor), TNF-α (tumor necrosis factor alpha), and the pro-inflammatory cytokines IL-6 (interleukin-6) and IL-1β (interleukin-1β) [14].
In addition to its antimicrobial properties, the wound-healing capacity of honey is also noted. Its activity can be both bacteriostatic and bactericidal, depending on the type of honey. When honey comes into contact with a wound, it reduces protease activity in the damaged area, increases oxygen release from hemoglobin, stimulates fibroblasts and macrophages. The production of hydrogen peroxide stimulates vascular endothelial growth factor and sterilizes the wound. Thus, honey can be used as a component incorporated into wound dressings [15].
In order to prevent the development of pathogenic microorganisms during burn healing, it is essential to maintain an optimal level of exudate. Honey possesses significant osmotic potential, which promotes the release of lymphatic fluid. This fluid, in turn, cleanses and disinfects the wound and aids in the removal of foreign particles from the wound bed. Due to its osmotic potential and the ability to absorb moisture, honey as a wound dressing significantly reduces the risk of swelling and skin wrinkling, protecting the wound from over-hydration [16][17].
In this study, we set out to develop hydrogels based on polymers and honey, conduct a comparative analysis of their physicochemical characteristics, and determine their antibacterial activity.
MATERIALS AND METHODS
The starting compounds were Far Eastern white (linden) honey purchased from the store “Honey & Confiture” (2023 harvest, article number: 00000001221 with a quality certificate from the supplier), high-viscosity chitosan (3.5%, Sigma-Aldrich), low-viscosity chitosan (3.5%, Sigma-Aldrich), Carbopol 940 (1%, Lubrizol), and Carbopol ETD 2020 (1%, Acros Organics).
Preparation of chitosan- and carbopol-based hydrogels
Hydrogels were prepared according to a standard protocol as follows. A weighed sample of chitosan was dissolved in a weak acetic acid solution using a Heidolph Silent Crusher M homogenizer (Germany) at a speed of 9000 rpm (Fig. 1). A weighed sample of Carbopol was dissolved in water using a homogenizer at 9000 rpm. The resulting polymer solutions were adjusted to a neutral pH (pH = 6.0–7.0) with triethanolamine (TEA) under continuous stirring. pH was monitored using a pH meter (pH-150MI, Russia). Polyethylene glycol (PEG) was used as a cross-linking agent and preservative. The resulting polymer solutions were left to stabilize and swell for 24 h in a refrigerator.

Figure prepared by the authors using their own data
Fig. 1. Protocol for the preparation of honey-containing hydrogel samples
Preparation of honey-containing hydrogels
White (linden) honey was liquefied in a drying oven at a temperature of 45°C and added to the hydrogels under constant stirring (Fig. 1). The following honey concentrations were selected for each polymer solution: 25, 50, and 75 wt %. The resulting hydrogels were stored in a refrigerator for 24 h to stabilize and ensure uniform honey distribution.
Viscometric analysis
The viscosity of the hydrogels was investigated using a Brookfield LV-SSR Brinell Viscometer rotational viscometer (China). The experiment for each sample was repeated three times. The average viscosity value was calculated.
Sorption capacity investigation
A phosphate buffer with a pH of 5.5, corresponding to the optimal pH of human skin, was prepared as follows: a 13.61 g sample of potassium dihydrogen phosphate was dissolved in water in a 1000 mL volumetric flask. A 3.58 g sample of disodium hydrogen phosphate was dissolved in water, bringing the solution to the 100 mL mark. Then, 964 mL of the potassium dihydrogen phosphate solution was mixed with 36 mL of the disodium hydrogen phosphate solution.
Dry samples were immersed in the phosphate buffer, ensuring their complete submergence. The samples were left for 1 h followed by draining excess liquid and weighing. The samples were then immersed in buffer again and weighed after another 2 h. The experiment was repeated three times for each sample; the average value for each sample was calculated.
The degree of swelling was determined by the amount of fluid absorbed per 1 g of dry substance, according to formula (1):
 (1)
(1)
where Q — hydrogel sorption capacity, g/g; m — mass of the swollen sample, g; m0 — initial mass of the sample, g; γ — moisture content of the gel sample, mass fraction.
The moisture content of the gel sample, mass fraction, equals:
 (2)
(2)
where m0 — initial mass of the sample, g; mc — mass of the sample dried to constant weight, g.
Spreadability study
The spreadability of the hydrogels was assessed using a compression method (Fig. 2) [18]. A 0.5 g sample of each formulation was placed between two glass slides. A 5 g weight was placed on the top slide, and, following 5 min, the diameters of the formed discs were measured using a ruler. Measurements were taken along three different axes. The experiment was repeated three times for each sample, with the average diameter being calculated for each formulation.

Figure prepared by the authors using their own data
Fig. 2. Methodology for spreadability testing
Hydrogel stability
Hydrogel stability was evaluated using a centrifugation method (Fig. 3). Each 15 mL sample was centrifuged (ZJMZYM Timing Medical Centrifuge, China) at 4000 rpm for 10 min. This was followed by a visual assessment of the samples for precipitate formation or phase separation. The experiment was repeated three times for each sample.

Figure prepared by the authors using their own data
Fig. 3. Methodology for stability testing. Honey release test from hydrogels
In accordance with the State Pharmacopoeia,1 a phosphate buffer with pH = 5.5 was selected as the model medium. The study utilized a ERWEKA DT-820 dissolution tester (Germany). A 500 mL volume of the dissolution medium was poured into a vessel thermostated in a water bath to a temperature of 32.0 ± 0.5°C. The sample holder was immersed into the vessel containing the dissolution medium, after which the apparatus with a rotational mechanism was started and operated for 4 h.
Samples were collected at hourly intervals. The samples were withdrawn from the mid-height region of the dissolution medium at a distance no closer than 10 mm from the inner wall of the vessel. The experiment was repeated three times for each sample, and the average value of the released substance was calculated for each formulation.
Spectrophotometric analysis of released honey
Quantitative analysis of honey in the buffer was performed using a Cary 100 UV Vis spectrophotometer (Agilent Technologies, USA). The absorption of the released honey was measured at a λmax of 340 nm (flavonoid peak).
Based on the obtained absorption values, the concentration of the active substance in each collected sample was calculated using formula (3):
 (3)
(3)
Ax, Ast — the absorbance values of the test solution and the standard solution, respectively; Cst — concentration of the active substance in the standard solution, g/mL.
In vitro antibacterial activity study
The following microorganisms were selected to study the antibacterial properties of the obtained samples: Candida albicans ATCC 64550 — a yeast-like fungus; Staphylococcus aureus ATCC 25913 — a gram-positive bacterium; Escherichia coli ATCC 25922 — a gram-negative bacterium; Acinetobacter baumannii 897 — a gram-negative bacterium; Enterobacter cloacae ATCC 13047 — a gram-negative bacterium; Klebsiella pneumoniae ATCC 19606 — a gram-negative bacterium. Mueller-Hinton agar (Research Center for Pharmacotherapy) was used as the nutrient medium for cultivating microorganisms via the disk-diffusion method. Nutrient Medium No. 1 GRM (State Research Center for Applied Microbiology and Biotechnology) was used for preliminary control of microbial contamination of the emulsions. Experiments to evaluate antibacterial properties were performed in accordance with the guidelines of the Clinical and Laboratory Standards Institute (CLSI)2 and the European Committee on Antimicrobial Susceptibility Testing (EUCAST).3
The agar was inoculated using streaking motions in three directions with a microbial suspension prepared in sterile physiological saline (density 5 × 10⁸ CFU/mL or 0.5 McFarland standard) to achieve a confluent lawn. Fifteen minutes after inoculation, disks impregnated with the hydrogel samples were placed in Petri dishes, which were then incubated with the microorganisms at 35 °C for 20 h. Upon completion of the incubation period, the diameters of the growth inhibition zones were measured with an accuracy of 1 mm. This was achieved by placing the Petri dishes upside down on a dark surface and illuminating them with a lamp at a 45-degree angle.4
Statistical data processing
Statistical data processing was performed using the DeltaX 3.0 software. A one-sample Student’s t-test was used for result analysis. Data are presented as mean value and standard deviation (SD).
RESULTS AND DISCUSSION
In order to compare the physicochemical properties of the hydrogels, samples with different honey weight concentrations (25, 50, and 75 wt %) were prepared. Visual assessment revealed that all samples with 25 and 50 wt % honey concentrations were similarly transparent and homogeneous, possessing a slight honey odor, and having a yellow (for 25 wt % concentration samples) or yellowish-brown color (for 50 wt % concentration samples). No mechanical inclusions were detected in these samples. Chitosan-based and carbopol-based samples with a 50 wt % honey concentration exhibited a viscous liquid consistency, unlike the carbopol-based samples with a 25 wt % honey concentration. The carbopol-based samples with a 25 wt % honey concentration had a gel-like structure.
An analysis of the potentiometric data (Table 1) showed that the addition of honey to the hydrogel composition contributed to a decrease in the pH value. It is known that depending on the skin type, the pH can vary 4–7. Since our results fall within the permissible range, honey-containing hydrogels can be considered suitable for transdermal administration.
Table 1. Results of potentiometric study*
|
Polymer name |
Honey concentration, wt % |
pH values of polymer solutions after adjustment with triethanolamine |
pH values of hydrogels after honey addition |
|
3.5% High-viscosity chitosan |
25 |
6.5 |
6.4 |
|
50 |
6.2 |
||
|
75 |
6.3 |
||
|
3.5% Low-viscosity chitosan |
25 |
6.3 |
6.2 |
|
50 |
6.3 |
||
|
75 |
5.3 |
||
|
1% Carbopol 940 |
25 |
6.3 |
6 |
|
50 |
5.8 |
||
|
75 |
5.7 |
||
|
1% Carbopol ETD 2020 |
25 |
6.3 |
5.9 |
|
50 |
5.8 |
||
|
75 |
5.7 |
Table compiled by the authors based on original data
Note: * the table presents average values.
The viscosity parameters of the samples also depended on the incorporation of honey into the hydrogel composition (Table 2). It was observed that viscosity decreased with an increase in honey concentration in the hydrogels. This trend was characteristic of all samples, except for those based on high-viscosity chitosan. The most suitable parameters for transdermal administration were exhibited by samples based on Carbopol 940 with a 25 wt % honey concentration.
Table 2. Results of hydrogel viscosity studies*
|
Polymer name |
Honey concentration, wt % |
Viscosity parameters of polymer solutions, cPs |
Viscosity parameters of hydrogels after honey addition, cPs |
|
3,5% High-viscosity chitosan |
25 |
9.2 |
7.2 |
|
50 |
4.9 |
||
|
75 |
6.8 |
||
|
3,5% Low-viscosity chitosan |
25 |
13.28 |
4.24 |
|
50 |
4.3 |
||
|
75 |
1.98 |
||
|
1% Carbopol 940 |
25 |
25.68 |
10.96 |
|
50 |
5.6 |
||
|
75 |
1.2 |
||
|
1% Carbopol ETD 2020 |
25 |
18.08 |
8 |
|
50 |
5.12 |
||
|
75 |
1.1 |
Table compiled by the authors based on original data
Note: * the table presents average values; cPs — centipoise.
To determine the sorption capacity of hydrogels, the moisture content of each sample was calculated in mass fractions using formula (2). The results of the moisture content calculations are presented in Table 3.
Table 3. Assessment of hydrogel swelling capacity*
|
Polymer name |
Honey concentration, wt % |
Moisture content, % |
Standard deviation (SD) |
|
3.5% High-viscosity chitosan |
25 |
0.63 |
0.03 |
|
50 |
0.65 |
0.02 |
|
|
3.5% Low-viscosity chitosan |
25 |
0.63 |
0.04 |
|
50 |
0.68 |
0.03 |
|
|
1% Carbopol 940 |
25 |
0.67 |
0.06 |
|
50 |
0.67 |
0.07 |
|
|
1% Carbopol ETD 2020 |
25 |
0.61 |
0.05 |
|
50 |
0.60 |
0.06 |
Table compiled by the authors based on original data
Note: * the table presents average values.
The data obtained on the sorption capacity of the hydrogels are presented in Table 4. Samples with the lowest honey concentration demonstrated the highest sorption capacity, regardless of the type of polymer they were based on. Observations were conducted over 1 h and 3 h. These time intervals were selected based on the anticipated exposure time of the future coating.
Table 4. Results of sorption capacity studies*
|
Polymer name |
Honey concentration, wt % |
Sorption capacity after 1 h |
Standard deviation (SD) |
Sorption capacity after 3 h |
Standard deviation (SD) |
|
3.5% High-viscosity chitosan |
25 |
10.44 |
0.09 |
7.24 |
0.05 |
|
50 |
2.74 |
0.08 |
0.53 |
0.07 |
|
|
3.5% Low-viscosity chitosan |
25 |
14.63 |
0.13 |
14.37 |
0.11 |
|
50 |
5.34 |
0.08 |
1.23 |
0.02 |
|
|
1% Carbopol 940 |
25 |
7.33 |
0.06 |
10.00 |
0.04 |
|
50 |
3.16 |
0.11 |
3.50 |
0.06 |
|
|
1% Carbopol ETD 2020 |
25 |
4.71 |
0.07 |
6.50 |
0.09 |
|
50 |
2.57 |
0.03 |
4.54 |
0.03 |
Table compiled by the authors based on original data
Note: * the table presents average values.
It is also noteworthy that the sorption capacity of chitosan-based hydrogels decreased after 3 h. This is associated with the relatively rapid release of the substance into the buffer medium observed in chitosan-based samples. This trend was clearly demonstrated in the release test. The opposite trend was observed in carbopol-based samples.
The greatest sorption performance was demonstrated by the sample based on low-viscosity chitosan with a 25 wt % honey concentration, both after 1 h and 3 h. This sample yielded the sorption capacity values of 14.63 g/g. Furthermore, no significant decrease in sorption capacity was observed after 3 h. The lowest performance levels were observed in the sample based on high-viscosity chitosan with a 50 wt % honey concentration. This sample exhibited a low sorption capacity of 2.74 g/g after 1 h of the experiment, and after 3 h, the sorption capacity decreased more than fivefold down to 0.53 g/g.
The spreadability study of the samples, including the standard deviation (SD), are presented in Table 5. It was found that an increase in honey concentration was associated with smaller droplet diameters, indicating reduced hydrogel spreadability. The comparison study revealed that the low-viscosity chitosan-based samples exhibited the highest spreadability. The smallest spreadability value of 0.55 cm was observed for samples based on Carbopol ETD 2020 with a 50 wt % honey concentration, as well as for samples based on high-viscosity chitosan with a 50 wt % honey concentration, making them more preferable for use as a transdermal coating. These data correlate with the results previously obtained by other authors [19]. Future research should investigate the spreadability of a hybrid hydrogel composed of Carbopol ETD 2020 and low-viscosity chitosan. Presumably, such a hydrogel would distribute better over the wound surface without spreading beyond its boundaries.
Table 5. Results of spreadability studies
|
Polymer name |
Honey concentration, wt % |
Mean value, cm |
Standard deviation (SD) |
|
3.5% High-viscosity chitosan |
25% |
1.03 |
0.09 |
|
50% |
0.76 |
0.07 |
|
|
3.5% Low-viscosity chitosan |
25% |
1.66 |
0.13 |
|
50% |
1.36 |
0.06 |
|
|
1% Carbopol 940 |
25% |
1.00 |
0.09 |
|
50% |
0.93 |
0.12 |
|
|
1% Carbopol ETD 2020 |
25% |
1.01 |
0.06 |
|
50% |
0.55 |
0.11 |
Table compiled by the authors based on original data
The stability study of the hydrogels revealed that all samples, except for those with a 75 wt % honey concentration, passed the test successfully. No precipitate formation or phase separation was detected after centrifugation.
For the study of honey release from hydrogels, samples based on 10% high-viscosity chitosan and 10% low-viscosity chitosan were prepared instead of the 3.5% samples. The sample based on low-viscosity chitosan with a 50 wt % honey concentration demonstrated the best honey release profile. This sample showed the highest rate of honey release as early as the first hour of the experiment. Subsequently, the release values continued to increase. For the other samples, only a slight increase in the concentration of released honey was characteristic. The study results are presented in Figure 4.

Figure prepared by the authors using their own data
Fig. 4. Results of honey release from hydrogels
Different varieties of floral honey exhibit pH values ranging 3.5–4.1. However, linden honey with pH varying 4.5–7 is an exception. A neutral or slightly alkaline environment is most favorable for the comfortable survival of most bacteria. If the environmental pH shifts strongly to the alkaline region (pH 8–14), cellular RNA and phospholipids are destroyed, leading to cell death. Conversely, when the environmental pH shifts to the acidic region (pH 1–6), DNA and ATP are degraded. An acidic environment is particularly detrimental to putrefactive bacteria.
The in vitro study demonstrated that samples based on both low-viscosity and high-viscosity chitosan, regardless of honey concentration, exhibited an antibacterial effect against Staphylococcus aureus bacteria (Fig. 5).

Photos taken by the authors
Fig. 5. Study of antibacterial properties of chitosan-based hydrogels against Staphylococcus aureus
Furthermore, samples based on both low- and high-viscosity chitosan with a 25 wt % honey concentration exhibited antibacterial properties against Acinetobacter baumannii bacteria (Fig. 6).
Photos taken by the authors
Fig. 6. Study of antibacterial properties of chitosan- and 25% honey-based hydrogels against Acinetobacter baumannii
The study also identified bacteriostatic properties — the ability to suppress the growth and development — in samples based on low-viscosity chitosan with a 25 wt % honey concentration, as well as in samples based on Carbopol ETD 2020 with a 25 wt % honey concentration (Fig. 7), against Klebsiella pneumoniae bacteria.

Photos taken by the authors
Fig. 7. Study of antibacterial properties of low-viscosity chitosan- and 25% honey-based hydrogels, as well as Carbopol ETD 2020-based hydrogel with 25% honey concentration, against Klebsiella pneumoniae
Furthermore, a weak bacteriostatic effect was observed from hydrogels based on both low- and high-viscosity chitosan with a 25 wt % honey concentration against Escherichia coli (Fig. 8) and Enterobacter cloacae (Fig. 9).

Photos taken by the authors
Fig. 8. Study of antibacterial properties of chitosan- and 25% honey-based hydrogels against Escherichia coli

Photos taken by the authors
Fig. 9. Study of antibacterial properties of chitosan- and 25% honey-based hydrogels against Enterobacter cloacae
The remaining samples did not exhibit antibacterial or bacteriostatic properties, which may be associated with weak honey release. Furthermore, no antifungal effect was detected from the samples, as tests against the yeast-like fungus Candida albicans yielded no results. This is likely due to the optimal pH for Candida albicans viability being 6.0–6.8.
However, it is important to note that the effects observed were demonstrated against “wild-type” strains of Acinetobacter baumannii, Klebsiella pneumoniae, and Escherichia coli. In the future, we plan to conduct a series of experiments on polyresistant hospital-acquired and community-acquired strains of the Gram-negative pathogens Acinetobacter baumannii, Klebsiella pneumoniae, and Escherichia coli.
CONCLUSIONS
- The hydrogel based on 1% Carbopol 940 with a 25 wt % honey concentration outperformed other samples in terms of viscosity. The hydrogel based on 3.5% low-viscosity chitosan showed the lowest viscosity value.
- The samples based on 1% Carbopol ETD 2020 with a 50% honey concentration exhibit the lowest spreadability. The highest spreadability was noted for 3.5% low-viscosity chitosan, making it an undesirable candidate as a transdermal coating base.
- To achieve a coating with optimal viscosity characteristics and spreadability, it is recommended to further investigate a mixed hydrogel composed of Carbopol 940 and low-viscosity chitosan.
- The greatest sorption capacity after 1 h and 3 h from the start of the test was demonstrated by the sample based on 3.5% low-viscosity chitosan with a 25% honey concentration.
- The highest honey release was demonstrated by the sample based on 10% low-viscosity chitosan with a 50% honey concentration. The sample based on 3.5% low-viscosity and high-viscosity chitosan proved unsuitable for further research.
- According to the results of antibacterial action studies, chitosan-based hydrogels were identified as the most promising samples for further investigation.
- The conducted study of the physicochemical parameters of the investigated hydrogels and their antibacterial properties allow us to recommend a mixed hydrogel based on Carbopol 940 and 3.5% low-viscosity chitosan for further investigation.
- The comparative analysis revealed hydrogel samples with a 75 wt % honey concentration to fail the stability test, making them unsuitable for use as a therapeutic delivery system.
Authors’ contributions. All authors confirm that their contributions meet the ICMJE authorship criteria. The primary contributions are distributed as follows: Ekaterina N. Karpina — sample preparation, investigation of their physicochemical properties, interpretation of the obtained results; Elena V. Fedotova — oversight during research planning and execution, data collection and analysis for the work, writing the initial draft of the manuscript, creation and preparation of the manuscript; Faliya F. Zaripova — investigation of the in vitro antibacterial properties of the samples, critical analysis of the manuscript draft, providing comments and revisions; Denis V. Krivorotov — data collection and analysis for the work, critical analysis of the work for scientific novelty; Andrey S. Radilov — formulation of the research objectives, provision of access to necessary research materials, reagents, substances, and laboratory samples, research design, final approval of the version for publication.
1. General pharmacopoeial monograph “Buffer Solutions”. OFS.1.3.0003 “State Pharmacopoeia of the Russian Federation. XV edition”. Accessed from the reference-legal system “Consultant Plus” (access date 21.07.2025).
2. CLSI. Performance Standards for Antimicrobial Susceptibility Testing. 33rd ed., CLSI supplement M100. Clinical and Laboratory Standards Institute; 2023.
3. EUCAST Disk Diffusion Method for Antimicrobial Susceptibility Testing Version 12.0 (January 2024). www.eucast.org
4. Methodological Guidelines. MUK 4.2.1890-04 “Control Methods. Biological and Microbiological Factors. Determination of Microorganism Susceptibility to Antibacterial Drugs” (approved by the Chief State Sanitary Physician of the Russian Federation on 04.03.2004). Accessed via the “Consultant Plus” system. (Access date 25.05.2025).
References
1. Bibire T, Panainte AD, Yilmaz CN, Timofte DV, Danila R, Bibire N, et al. Dexketoprofen-Loaded Alginate-Grafted Poly(N-vinylcaprolactam)-Based Hydrogel for Wound Healing. International Journal of Molecular Sciences. 2025;26(7):3051. https://doi.org/10.3390/ijms26073051
2. Surowiecka A, Struzyna J, Winiarska A, Korzeniowski T. Hydrogels in Burn Wound Management–A Review. Gels. 2022;8:122. https://doi.org/10.3390/gels8020122
3. Yao Y, Zhang A, Yuan C, Chen X, Liu Y. Recent trends on burn wound care: Hydrogel dressings and scaffolds. Biomaterials Science. 2021;9(13):4523–40. https://doi.org/10.1039/d1bm00411e
4. Chornopyshchuk R, Nagaichuk V, Gerashchenko I, Nazarchuk H, Kukolevska O, Choropyshchuk N, et al. Antimicrobial properties of a new polymeric material based on poly (2-hydroxyethyl methacrylate). Acta Bio-Medica: Atenei Parmensis. 2022;93(1):e2022012.
5. Romero-Antolin JA, Gomez-Cerezo N, Manzano M, Pablos JL, Valet-Regi M. Anti-inflammatory and Antibacterial Hydrogel Based on a Polymerizable Ionic Liquid. Acta Biomaterialia. 2025;196:78–92. https://doi.org/10.1016/j.actbio.2025.03.015
6. Maikovych O, Nosova N, Bukartyk N, Fihurka N, Ostapiv D, Samaryk V, et al. Gelatin-based hydrogel with antiseptic properties: synthesis and properties. Applied Nanoscience. 2023;13(12):7611–23. https://doi.org/10.1007/s13204-023-02956-6
7. Amanzholkyzy A, Zhumagaliyeva S, Sultanova N, Abilov Z, Ongalbek D, Donbayeva E, et al. Hydrogel Delivery System for Biological Active Substances: Properties and the Role of HPMC as a Carrier. Molecules. 2025;30(6):1354. https://doi.org/10.3390/molecules30061354
8. Li M, Qu H, Li Q, Lu S, Wu Y, Tang Z, et al. A carboxymethyl cellulose/chitosan-based hydrogel harvests robust adhesive, on-demand detachment and self-healing performances for deep burn healing. Chemical Engineering Journal. 2024;498:155552. https://doi.org/10.1016/j.cej.2024.155552
9. Nweze JA, Olovo CE, Nweze EI, Okechukwu OJ, Chidebelu P. Therapeutic Properties of Honey. In: de Toledo VA, Chambo ED, editors. Honey Analysis: New Advances and Challenges. London: IntechOpen; 2020:17–39. https://doi.org/10.5772/intechopen.86416
10. Albaridi NA. Antibacterial Potency of Honey. International Journal of Microbiology. 2019:1–10. https://doi.org/10.1155/2019/2464507
11. Sayadi SA, Zohdi RM, Shamshuddin NSS, Khairy MS, Hasan NA, Yasin AS, et al. Antifungal activity of selected Malaysian honeys: a comparison with Manuka honey. Journal of Coastal Life Medicine. 2015;3(7):539–42.
12. Francois AE, Gbaguidi B, Paraiso AA, Dah-Nouvlessounon D, Goubalan E, Baba-Moussa F, et al. Polyphenolic profile, and antioxidant and antifungal activities of honey products in Benin. African Journal of Microbiology Research. 2018;12(1):9–18. https://doi.org/10.5897/AJMR2017.8749
13. Khan RU, Naz S, Abudabos AM. Towards a better understanding of the therapeutic applications and corresponding mechanisms of action of honey. Environmental Science and Pollution Research. 2017;24(36):27755–66. https://doi.org/10.1007/s11356-017-0567-0
14. Talebi M, Talebi M, Farkhondeh T, Samarghandian S. Molecular mechanism-based therapeutic properties of honey. Biomedicine & Pharmacotherapy. 2020;130:110590. https://doi.org/10.1016/j.biopha.2020.110590
15. Tashkandi H. Honey in wound healing: An updated review. Open Life Sciences. 2021;16(1):1091–100. https://doi.org/10.1515/biol-2021-0084
16. Bahari N, Hashim N, Akim AM, Maringgal B. Recent Advances in Honey-Based Nanoparticles for Wound Dressing: A Review. Nanomaterials. 2022;12(15):2560. https://doi.org/10.3390/nano12152560
17. Molan P.C. Potential of Honey in the Treatment of Wounds and Burns. American Journal of Clinical Dermatology. 2001;2(1):13–9. https://doi.org/10.2165/00128071-200102010-00003
18. El-Kased RF, Amer RI, Attia D, Elmazar MM. Honey-Based Hydrogel: In Vitro and In Vivo Evaluation for Burn Wound Healing. Scientific Reports. 2017;7:9692. https://doi.org/10.1038/s41598-017-08771-8
About the Authors
E. N. KarpinaRussian Federation
Ekaterina N. Karpina
St. Petersburg
E. V. Fedotova
Russian Federation
Elena V. Fedotova, Cand. Sci. (Chem.)
St. Petersburg;
Kuzmolovsky, Leningrad region
F. F. Zaripova
Russian Federation
Faliya F. Zaripova, Cand. Sci. (Biol.)
St. Petersburg
D. V. Krivorotov
Russian Federation
Denis V. Krivorotov, Cand. Sci. (Chem.)
Kuzmolovsky, Leningrad region
A. S. Radilov
Russian Federation
Andrey S. Radilov, Dr. Sci. (Med.), Professor
Kuzmolovsky, Leningrad region
Review
For citations:
Karpina E.N., Fedotova E.V., Zaripova F.F., Krivorotov D.V., Radilov A.S. Honey-based hydrogel: A promising new-generation antimicrobial coating? Extreme Medicine. 2026;28(1):146-156. https://doi.org/10.47183/mes.2025-347
JATS XML
















